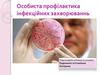
Особиста профілактика інфекційних захворюваннь

Similar presentations:
Інфекцйні захворювання
1. Інфекцйні захворювання
ПідготувалаУчениця 10-Б класу
Гурба Анастасія
2. Інфекційні хвороби
3.
Інфекційні хвороби («infectio» — зараження) — цегрупа захворювань, які викликаються
проникненням в організм хвороботворних
мікроорганізмів. Щоб патогенний мікроб, який
потрапив в організм, міг викликати інфекційні
хвороби, він повинен бути долати опірність
людського організму і чинити на нього токсичну
дію. Ці якості фахівці називають вірулентністю.
Деякі патогенні мікроорганізми вивільняють
токсини, в процесі саморуйнування. Інші
збудники інфекційних захворювань виділяють
токсини у процесі своєї життєдіяльності.
На частку інфекційних хвороб припадає 20-40% від
загального числа всіх захворювань людини.
Вивченням, питаннями профілактики, діагностики
та лікування інфекційних захворювань займаються
такі мікробіологічні та медичні дисципліни, як
урологія, венерологія, епідеміологія, терапія,
гінекологія, фтизіатрія, імунологія, отоларингологія,
вірусологія і, звичайно, розділ медицини
«інфекційні хвороби».
4. Стадіі захворювання:
момент зараження — відбувається проникненняхвороботворних мікробів в організм;
інкубаційний (прихований, латентний) період —
триває з моменту інфікування до прояву перших
симптомів захворювання;
продромальний період (провісник захворювання) —
супроводжується невеликим підвищенням
температури, головним болем, почуттям розбитості,
загальним нездужанням;
період наростання захворювання — відбувається
послідовне поява ознак, характерних для певної
хвороби;
розпал хвороби — час яскраво вираженого прояву
всіх специфічних для захворювання симптомів;
період згасання захворювання — супроводжується
зникненням клінічних ознак захворювання з швидким
(криза) або повільним (лізис) падінням температури;
еріод одужання — тривалість залежить від загального
стану організму, умов, в яких знаходиться пацієнт,
тяжкості перенесеного захворювання.
5. Види профілактики інфекційних захворювань
Первинна профілактика:система заходів попередження виникнення та впливу факторів ризику
розвитку захворювань (вакцинація, раціональний режим праці і відпочинку,
раціональне якісне харчування, фізична активність, охорона навколишнього
середовища і т. д.). Ряд заходів первинної профілактики може здійснюватися в
масштабах держави.
Вторинна профілактика:
комплекс заходів, спрямованих на усунення виражених чинників ризику, які за
певних умов (стрес, ослаблення імунітету, надмірні навантаження на будь-які
інші функціональні системи організму) можуть призвести до виникнення,
загострення і рецидиву захворювання. Найбільш ефективним методом
вторинної профілактики є диспансеризація як комплексний метод раннього
виявлення захворювань, динамічного спостереження, спрямованого лікування,
раціонального послідовного оздоровлення.
Третинна профілактика
Деякі фахівці пропонують термін третинна профілактика як комплекс заходів,
з реабілітації хворих, які втратили можливість повноцінної життєдіяльності.
Третинна профілактика має на меті соціальну (формування впевненості у
власній соціальної придатності), трудову (можливість відновлення трудових
навичок), психологічну (відновлення поведінкової активності) і медичну
(відновлення функцій органів і систем організму) реабілітацію.
6. Профілактика інфекційних захворювань
Лікування інфекційних захворювань зазвичай проводиться у спеціалізованихвідділеннях стаціонарів, в легких випадках можливе лікування в домашніх
умовах. Суворе дотримання протиепідемічного режиму є обов’язковою
умовою.
Сучасна медицина створила і успішно використовує велику кількість
ефективних лікарських засобів. Це антибіотики, вакцини (застосовуються
для профілактики інфекційних захворювань), імуноглобуліни різного роду,
бактеріофаги і т.д.
Велике значення надається вихованню охайності у людей. Звичайне миття
рук після відвідин убиральні, виконання брудної роботи, перед їжею вже
може вберегти від багатьох кишкових інфекцій.
Джерелом інфекції можуть бути не тільки місця загального користування,
але й гроші, поручні у транспорті, поверхня прилавків і багато іншого.
Куплені фрукти і овочі можуть бути джерелом гельмінтів та інших
небезпечних мікробів, тому їх обов’язково потрібно ретельно вимивати
перед вживанням.
Інфекційними носіями є таргани і гризуни, для боротьби з якими
промисловість виробляє різноманітні засоби, якими необхідно обробляти
місця їх скупчення і розповсюдження.
Не можна скидати з рахунків комарів і кліщів. Ці комахи особливо
небезпечні, оскільки переносять не тільки енцефаліт та малярію, але і СНІД
разом з кров’ю інфікованої людини. Для захисту від кліщів і комарів існує
безліч кремів і аерозолів для нанесення на одяг, а також фумігаторів і
відлякувачів.
7. Антибіотики
Антибіотики вбивають бактерії, або блокують їхнє розмноження. На цьому їхні"обов"язки" в процесі лікування закінчуються. Багато любителів самолікування
помилково приймають їх при будь-яких запаленнях, проте при вірусній
інфекції вони абсолютно безсилі.
Хоча антибіотики і "налаштовані" насамперед на знищення бактерій, вони
токсичні і для нас з вами. Причому отруюють вони практично весь організм.
Насамперед удар приймає, безумовно, печінка. Але окрім неї страждає
також і імунна система, нирки і інші органи (залежно від конкретного
препарату).
Крім того, антибактеріальні препарати смертельні не тільки для
хвороботворних бактерій, але і для нашої власної мікрофлори. Таким чином,
ці ліки "б"ють" по нашому захисту з двох напрямів: пригнічують імунну систему
і знищують корисні бактерії у слизових оболонках.
Крім того, під впливом антибіотиків хвороботворні бактерії проходять
специфічний еволюційний відбір, в результаті якого утворюються лінії мутантів.
Ці нові форми бактерій не тільки нечутливі до дії старих препаратів, але часто
також легше "тікають" від нашої імунної системи, що робить їх удвічі
небезпечнішими.
Не дивлячись на таку велику кількість негативних рис, у ряді випадків без
антибактеріальних препаратів не обійтися. Насамперед вони незамінні при
бактерійних інфекціях. У таких випадках вибір препарату і дозування повинен
робити лікар на основі бактерійного посіву (правда до отримання його
результатів часто доводиться призначати ліки на основі непрямих симптомів).
8. Щеплення та методи їх виконання
9.
Вакцина́ція — введення антигенного матеріалу з метоювикликати імунітет до хвороби, який допоможе запобігти зараження, чи
послабить його наслідки
Всі вакцини підрозділяються:
Живі вакцини готують з мікробів з ослабленою вірулентністю.
Убиті вакцини отримують з культур мікроорганізмів, убитих нагріванням,
дією формаліну або інших хімічних речовин. Убиті (нагріті) вакцини
застосовуються проти кишкових інфекцій, кашлюку, висипного тифу,
Ку-лихоманки, енцефалітів. Імунної та ефективність убитих вакцин значно нижче, ніж живих. Вони створюють імунітет тривалістю від 6 до 12
міс. І для тривалої підтримки несприйнятливості організму до інфекції
повинні вводитися повторно.
Хімічні вакцини містять специфічні антигенні компоненти, витягнуті з
мікробних клітин різними способами. Хімічні вакцини, що складаються
з повних антигенів збудників черевного тифу і парафітов,
застосовуються для специфічної профілактики тифо-паратифозних
інфекцій.
10. Методи виконання
Внутрішньом'язове введення вакцин є основним способом імунізаціїсорбованих препаратами. В цьому випадку місцева реакція слабо
виражена. У хворих на гемофілію, через можливість кровотечі, слід
застосовувати підшкірний метод введення вакцин.
Підшкірна вакцинація зазвичай використовується для несорбірованних
вакцин. Вакцину вводять в подлопаточную область або в ділянку зовнішньої
поверхні плеча на рівні межі верхньої і середньої третин плеча. реакціі на
вакцину при підшкірному введенні під лопатку менш виражені в порівнянні з
підшкірним введенням в інші ділянки тіла. Розчинні вакцини зберігаються в
підшкірній клітковині до 5 днів, а сорбованих препарати - до 1 міс і більше.
Незважаючи на широке застосування підшкірного і внутрішньом'язового
методів вони мають ряд недоліків: можливість порушення правил асептики,
необхідність використання разових шприців, мала продуктивність ін.
Внутрішньошкірної метод застосовується для введення БЦЖ вакцини.
Вакцину вводять в область зовнішньої поверхні плеча. Цей спосіб вимагає
певної навички, вакцину вводять під тиском до появи «лимонної скориночки».
При неправильному введенні БЦЖ вакцини існує небезпека утворення
холодного абсцесу.
Нашкірний спосіб вакцинації , широко застосовуваний для профілактики
віспи, використовується головним чином для імунізації живими вакцинами
проти особливо небезпечних інфекцій (чума, туляремія, сибірська виразка,
бруцельоз, лихоманка Ку). Нашкірний метод дозволяє максимально
знизити реактогенність вакцини, проте нестандартність дозування
препарату і техніки скарифікації, а також мала продуктивність обмежують
сферу застосування цього методу.











 medicine
medicine